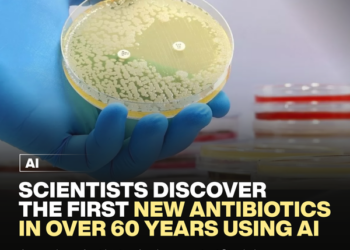
Scientists discover the first new antibiotics in over 60 years using AI 9 Scientists Discover the new antibiotics in over 60 years

UK Stands to Lose 8 Million Jobs From AI, Analysis Warns
In a recent analysis conducted by the Institute for Public Policy Research (IPPR), it has been revealed that up to eight million workers in the United Kingdom are at risk of losing their jobs to artificial intelligence (AI) if current government policies remain unchanged. The report, published on Wednesday,...
Read more